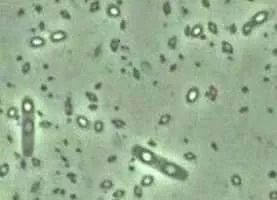

Bacillus Thuringiensis
| Use attributes for filter ! | |
| Class | Bacilli |
|---|---|
| Scientific name | Bacillus thuringiensis |
| Rank | Species |
| Higher classification | Bacillus |
| Phylum | Firmicutes |
| Did you know | In addition to Ba, Bc, Bt and Bm, there are two other highly related species B. pseudomycoides (Bpm) and B. weihenstephanensi (Bw) in the BC group. |
| Date of Reg. | |
| Date of Upd. | |
| ID | 950591 |
About Bacillus Thuringiensis
Bacillus thuringiensis is a Gram-positive, soil-dwelling bacterium, commonly used as a biological pesticide.